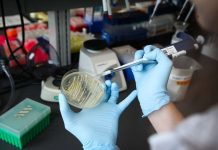
Stanford biochemists produce opiates with yeast and sugar Stanford biochemists produce opiates with yeast and sugar

Researchers have developed gene-edited barley that could better your beer
After a spell of unexpected rain, before the harvest season, a farmer may be faced with the unpredictable problem of untimely sprouting of barley....
Study: The ultrastructure of huntingtin inclusions revealed
Huntington’s disease is a progressively debilitating brain disease that causes uncontrolled movements, psychological problems, and loss of cognition. Huntington’s is caused by a mutation...
How soil quality affects human health and nutrition
We often hear about the healthy vitamins and nutrients that we get from eating certain vegetables, fruits, nuts, and grains and how essential they...
Genomic data shows that humans do not mate completely at random
In a new study from the University of Colorado Boulder, the genomes of 825 non-Hispanic white American couples were examined to the determination that...
New research proves light can be converted into matter by man
Oliver Pike and physicists from the Imperial College London have developed a method to convert light into matter.
Perhaps fittingly, the basic theory that provided...
When AI gets it wrong, this UTA computer scientist wants to explain why
A University of Texas at Arlington computer scientist has earned a three-year, $385,000 grant from the National Institute of Standards and Technology to analyze...
Study: Size matters for bee ‘superorganism’ colonies
Scientists have carefully studied the intricacies of how individual organisms live and act together in groups known as biological collectives. In “superorganisms” such as...
Stanford biochemists produce opiates with yeast and sugar
Pain relief is a necessity to many people in all parts of the world. Opiates grown from plants are the present source or opiates...
Research shows why nitrous oxide emissions should factor into climate change mitigation
Poorly drained agricultural soils emit enough of the greenhouse gas nitrous oxide that the resulting climate change effects could far exceed the benefits of...
Viable method developed to convert CO2 to carbon nanofibers
Many researchers have attempted to find a use for the increasing level of carbon dioxide (CO2) in the atmosphere in order to reduce the...
Top News
Hey ISIS, You Suck: Local Muslims Post Anti-ISIS Billboard
A new billboard on Manchester Road in Missouri reads, "HEY ISIS, YOU SUCK!!! From: #ActualMuslims."
A group of Muslim-Americans have put up a blunt billboard...